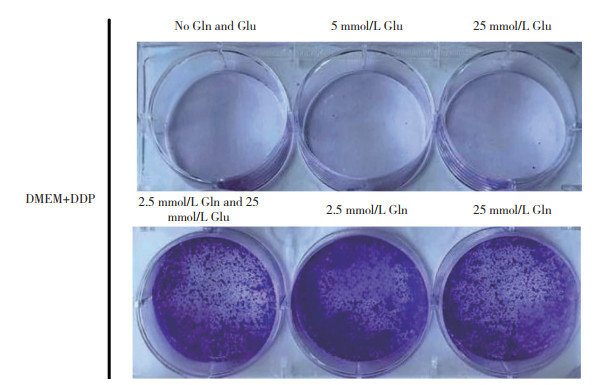
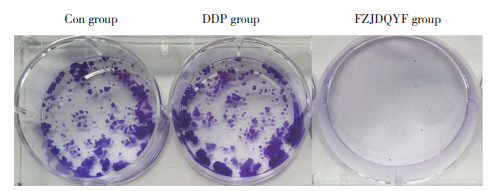

文章信息
- 赵辰辰, 吴彤, 李竹庭
- ZHAO Chenchen, WU Tong, LI Zhuting
- 扶正解毒祛瘀方通过改变谷氨酰胺代谢抑制非小细胞肺癌顺铂耐药
- Fuzheng Jiedu Quyu formula suppresses cisplatin resistance in non-small cell lung cancer by modulating glutamine metabolism
- 中国医科大学学报, 2026, 55(3): 206-211, 220
- Journal of China Medical University, 2026, 55(3): 206-211, 220
-
文章历史
- 收稿日期:2025-06-24
- 网络出版时间:2026-03-24 13:10:35
2. 天津中医药大学第二附属医院心血管内科, 天津 300250
2. Department of Cardiovascular Medicine, The Second Affiliated Hospital of Tianjin University of Traditional Chinese Medicine, Tianjin 300250, China
肺癌是全球癌症相关死亡的主要原因,其中非小细胞肺癌(non small cell lung cancer,NSCLC)约占85% [1]。早期NSCLC主要采用手术治疗,但手术治疗后患者复发率高,常需要进行化疗[2]。顺铂是一种细胞周期非特异性抗肿瘤药,对增殖期和非增殖期细胞均有作用,具有广泛的抗肿瘤活性,是NSCLC化疗的主流药物[3]。然而研究[3]显示,许多NSCLC患者会对顺铂产生耐药性。因此,明确NSCLC的耐药机制对其治疗至关重要。
谷氨酰胺是一种信号分子,与癌细胞内信号通路协同作用,促进肿瘤细胞生长增殖[4]。有研究[5]发现肿瘤细胞通过增加谷氨酰胺分解代谢以满足肿瘤细胞能量和生物合成需求,促进肿瘤细胞顺铂耐药。扶正解毒祛瘀方(Fuzheng Jiedu Quyu formula,FZJDQYF)出自我国名中医贾英杰教授,临床上已被证实对化疗具有减毒增敏的效果[6-9]。已有研究[10]显示,FZJDQYF联和顺铂能够改善肺癌小鼠免疫功能,抑制肿瘤细胞免疫逃逸。本研究探讨FZJDQYF抑制NSCLC顺铂耐药的机制,旨在为FZJDQYF治疗NSCLC顺铂耐药提供依据。
1 材料与方法 1.1 实验动物和细胞40只SPF级雄性C57BL/6小鼠购自北京贝优生物科技有限公司,体重(20±2)g,6~8周龄,许可证号SYXK(京)2024-0065。小鼠饲养于中国医学科学院放射医学研究所实验动物中心。饲养环境温度(25±2)℃,相对湿度(50±10)%,小鼠自由摄食。A549细胞和A549/DDP细胞均购自中国科学院细胞库。本研究获得细胞生态海河实验室实验动物福利伦理委员会批准(HH-DWLL-YW2025010-1)。
1.2 主要药物、试剂和仪器FZJDQYF含生黄芪30 g、太子参15 g、姜黄15 g、郁金10 g、夏枯草10 g、白花蛇舌草10 g、牡蛎15 g(先煎)、蜂房10 g,由天津中医药大学第二附属医院中药房制作并进行质量控制。顺铂(齐鲁制药集团有限公司,3E003C88),谷氨酰胺(河南盈欣生物科技有限公司,20240312),NADPH/NADP+检测试剂盒、ROS检测试剂盒、CCK-8检测试剂盒(上海碧云天生物技术股份有限公司),谷氨酰胺检测试剂盒、谷氨酰胺转运蛋白(solute carrier family 1 member 5,SLC1A5)抗体、谷氨酰胺酶(glutaminase,GLS)抗体、多药耐药相关蛋白2(multidrug resistance-associated protein 2,MRP2)、多药耐药基因1(multidrug resistance 1,MDR1)、P-糖蛋白(P-glycoprotein,Pgp)、肺耐药相关蛋白(lung resistance-related protein,LRP)(英国abcam公司)。Seahorse XF细胞能量代谢分析仪(美国安捷伦公司,XF24),多功能酶标仪(美国赛默飞世尔科技公司,Varioskan LUX),全自动凝胶成像分析系统(美国赛默飞世尔科技公司,EVOSTM M7000),流式细胞仪(德国贝克曼公司,CytoFLEX S)。
1.3 小鼠含药血清的制备取12只小鼠按照数字表法随机分为低剂量、中剂量和高剂量3组,每组4只。参考文献[11]实验方法,3组小鼠分别按照低剂量(正常剂量,1.5 g/kg)、中剂量(7.5 g/kg)和高剂量(15 g/kg)0.2 mL FZJDQYF灌胃,持续14 d。末次灌胃1 h后,给予巴比妥钠麻醉,腹主动脉采血,静置分层后2 500 r/min离心10 min,获取的血清于56 ℃的水浴锅中灭活补体30 min,然后经过滤膜(孔径为0.22 μm)过滤除菌,分装后于-20 ℃冰箱保存备用。
1.4 细胞分组将A549/DDP细胞在仅含谷氨酰胺的培养基中培养后,分为正常组(Con组,未处理)、顺铂组(DDP组,0.15 μmol/L顺铂处理14 d),FZJDQYF组(0.15μmol/L顺铂和15 g/mL FZJDQYF灌胃的小鼠含药血清共同处理14 d)。
1.5 方法 1.5.1 线粒体氧消耗率(oxygen consumption rate,OCR)检测先将各组细胞以1.5×104/孔接种于24孔板培养,24 h后将培养基更换成不含酚红和碳酸氢盐的DMEM培养基。随后将细胞放置于37 ℃不含CO2的细胞培养箱中平衡CO2水平。Seahorse XF细胞能量代谢分析仪检测各组细胞OCR,结果使用WAVE软件进行计算。
1.5.2 NADPH/NADP+水平检测使用NADPH/NADP+提取缓冲液提取细胞,采用试剂盒检测NADPH/NADP+水平。
1.5.3 活性氧(reactive oxygen species,ROS)检测在20 μmol/L DCFH-DA中于37 ℃孵育细胞30 min,并测定ROS介导的氧化产物2’,7’-二氯荧光素(2’,7’-dichlorofluorescein,DCF)。使用流式细胞仪检测在488 nm和535 nm时DCF的荧光值。根据DCF荧光值计算ROS水平。
1.5.4 集落形成实验将处于对数生长期的A549或A549/DDP细胞以3×103/孔接种于6孔板中,放置于37 ℃ 5%CO2培养箱培养24 h。然后加入不同浓度(0、5和25 mmol/L)、葡萄糖2.5 mmol/L谷氨酰胺的培养基中培养,并将A549或A549/DDP细胞加入0.15 μmol/L顺铂处理14 d,加入0.15 μmol/L顺铂和高剂量FZJDQYF灌胃的小鼠含药血清共同处理14 d。完成培养后弃去培养基,用4 ℃预冷的PBS溶液轻柔洗涤细胞2~3次后弃去PBS,加入4%多聚甲醛固定15 min,用蒸馏水清洗2 min,加入结晶紫染色液染色10 min,然后使用蒸馏水洗涤6孔板并干燥,倒置显微镜下观察,计数50个以上细胞克隆并拍照,计算集落形成率。集落形成率(%)=(集落数/接种细胞数)× 100。
1.5.5 谷氨酰胺水平检测将细胞以1×103/孔接种于24孔板。使用试剂盒检测各组细胞谷氨酰胺水平。
1.5.6 CCK-8实验将A549/DDP细胞用DMEM/F12完全培养液稀释,以5×103/孔接种于96孔板中,每组设置6个复孔,放置于37 ℃ 5%CO2培养箱,待细胞自然沉降并贴壁后(约4 h),加入0.15 μmol/L顺铂和低、中、高剂量FZJDQYF灌胃的小鼠含药血清处理48 h,弃去细胞上层培养液,加入CCK-8试剂37 ℃孵育30 min,于450 nm下测定吸光度值,根据吸光度值计算细胞存活率。
1.5.7 Western blotting检测提取各组细胞总蛋白,按照上样、SDS-PAGE蛋白分离电泳、转膜至PVDF膜、血清封闭、一抗孵育过夜、二抗孵育,ECL显色剂显色,全自动凝胶成像分析系统显像,利用ImageJ软件分析蛋白的相对表达量。
1.6 统计学分析使用SPSS 23.0软件进行统计分析。计量资料采用x±s表示。2组间比较采用非配对双尾t检验;多组间比较采用单因素方差分析(ANOVA)后,两两比较采用Bonferroni校正。P < 0.05为差异有统计学意义。
2 结果 2.1 谷氨酰胺通过促进NADPH的生成和抑制ROS的产生促进A549细胞顺铂耐药 2.1.1 谷氨酰胺或葡萄糖对顺铂诱导的A549细胞死亡的影响结果显示,当A549细胞在不含谷氨酰胺或含葡萄糖的培养基中培养时,顺铂能够明显促进A549细胞死亡,而在谷氨酰胺培养基中培养时能够明显逆转顺铂诱导的A549细胞死亡。见图 1。
|
| Gln, glutamine; Glu, glucose; DDP, cis-dichlorodiammine plalinum (Ⅱ). 图 1 克隆形成实验检测A549细胞的集落形成情况 Fig.1 The colony formation of A549 cells cultured through the colony formation assay |
2.1.2 A549、A549/DDP细胞OCR、NADPH/NADP+和ROS水平比较
结果显示,与A549细胞相比,A549/DDP细胞OCR明显升高(P < 0.05);顺铂处理后与A549细胞相比,A549/DDP细胞NADPH/NADP+升高,而ROS水平降低(P < 0.05)。见图 2、表 1。

|
| FCCP, carbonyl cyanide 4-(trifluoromethoxy) phenylhydrazone; Rot/AA, rotenone/antimycin A. 图 2 A549、A549/DDP细胞OCR的变化 Fig.2 Change of OCR values of A549 cells and A549/DDP cells |
| Group | OCR(pmol·min-1) | NADPH/NADP+ratio | ROS | |
| Basal | Max | |||
| A549 | 100.15±7.25 | 150.23±8.16 | 0.001±0.000 1 | 0.45±0.02 |
| A549/DDP | 303.24±6.981) | 395.26±10.321) | 0.003±0.000 21) | 0.10±0.031) |
| 1)P < 0.05 vs. A549 cells. | ||||
2.2 FZJDQYF调控谷氨酸代谢抑制A549/DDP细胞顺铂耐药 2.2.1 FZJDQYF对顺铂诱导的A549/DDP细胞存活率的影响
1.5、7.5、15 g/mL FZJDQYF小鼠灌胃制备的含药血清联合0.15 μmol/L顺铂处理A549/DDP细胞以及单独使用0.15 μmol/L顺铂处理A549/DDP细胞48 h。CCK-8检测结果显示,其细胞存活率分别为(61.56±2.54)%、(50.14±3.43)%、(43.23±1.78)%和(70.32±1.06)%。与单独使用顺铂处理的A549/DDP细胞相比,不同浓度含药血清联合顺铂处理的细胞存活率更低(P < 0.05,P < 0.01,P < 0.001),且呈剂量依赖性。因此,选用15 g/mL FZJDQYF小鼠灌胃的含药血清用于后续实验。
2.2.2 FZJDQYF对顺铂诱导的A549/DDP细胞谷氨酰胺代谢的影响与Con组相比,DDP组集落形成率无明显变化(P > 0.05),谷氨酰胺摄取量增加(P < 0.05),OCR、NADPH/NADP+升高(P < 0.05),ROS降低(P < 0.05);与DDP组相比,FZJDQYF组集落形成率降低(P < 0.05),谷氨酰胺摄取量降低(P < 0.05),OCR、NADPH/NADP+降低(P < 0.05),ROS升高(P < 0.05)。见图 3、表 2。
|
| 图 3 集落形成实验检测A549/DDP细胞集落形成情况 Fig.3 The colony formation of A549/DDP cells in each group by colony formation experiment |
| Group | Colony formation rate(%) | Glutamine uptake(μmol) | OCR(pmol·min-1) | NADPH/NADP+ratio | ROS | |
| Basal | Max | |||||
| Con | 44.24±11.21 | 678.33±3.54 | 500.65±3.78 | 350.78±4.34 | 0.034±0.000 5 | 0.551±0.012 |
| DDP | 46.88±13.131) | 1 300.55±1.221) | 768.24±6.981) | 495.26±8.121) | 0.223±0.000 21) | 0.304±0.0031) |
| FZJDQYF | 1.88±1.012) | 1 100.15±2.782) | 358.12±7.322) | 431.35±5.352) | 0.113±0.000 52) | 0.417±0.0042) |
2.3 FZJDQYF调控谷氨酸代谢相关通路抑制A549/DDP细胞顺铂耐药
Western blotting检测结果显示,与Con组相比,DDP组SLC1A5、GLS、MRP2、MDR1、Pgp和LRP表达均升高(P < 0.05);与DDP组相比,FZJDQYF组SLC1A5、GLS、MRP2、MDR1、Pgp和LRP表达均降低(P < 0.05)。见表 3、图 4。
| Group | SLC1A5 | GLS | MRP2 | MDR1 | Pgp | LRP |
| Con | 0.08±0.01 | 0.13±0.02 | 0.14±0.03 | 0.09±0.02 | 0.08±0.01 | 0.18±0.04 |
| DDP | 1.44±0.131) | 1.25±0.051) | 1.67±0.031) | 2.15±0.121) | 3.25±0.021) | 2.56±0.121) |
| FZJDQYF | 0.82±0.032) | 0.78±0.032) | 0.98±0.052) | 1.56±0.052) | 1.15±0.022) | 0.87±0.022) |
| 1)P < 0.05 vs. Con group;2)P < 0.01 vs. DDP group. | ||||||

|
| 1, Con group; 2, DDP group; 3, FZJDQYF group. 图 4 各组A549/DDP细胞SLC1A5、GLS、MRP2、MDR1、Pgp和LRP蛋白表达 Fig.4 Expression of SLC1A5, GLS, MRP2, MDR1, Pgp and LRP proteins of A549/DDP cells in each group |
3 讨论
分子免疫及靶向药物等干预手段广泛使用,但以铂类药物为基础的联合化疗仍为治疗NSCLC的首选方案;其引起的多发耐药性严重影响临床治疗效果[12-13]。
已有研究[14-15]证实多种肿瘤细胞中谷氨酰胺异常升高,为肿瘤细胞生长提供能量、稳定的氧化还原环境和大分子物质合成底物,同时也为治疗肿瘤提供了新的靶点。有研究[16]表明,表皮生长因子受体(epidermal growth factor receptor,EGFR)突变能显著上调SLC1A5的表达,进而增加谷氨酰胺的代谢。谷氨酰胺代谢产物可以活化EGFR下游信号,包括mTOR、ERK1/2、STAT3等,成为NSCLC对EGFR酪氨酸激酶抑制剂敏感性降低的重要原因[17]。然而,关于谷氨酰胺代谢与NSCLC顺铂耐药相关报道研究较少。仅有研究[18]发现,当NSCLC顺铂耐药在获得顺铂耐药表型的同时增强了对代谢压力(如谷氨酰胺剥夺)的适应性。
FZJDQYF含黄芪、太子参、姜黄、郁金、夏枯草等多味药材,它通过黄芪、太子参等来增强患者的机体免疫功能,扶助正气[19]。夏枯草、百花蛇舌草等含有多种活性成分,主要通过调节机体免疫功能、抑制肿瘤组织血管及淋巴管生成、诱导肿瘤细胞凋亡、调控相关信号通路、抗氧化等途径发挥对肿瘤细胞的抑制作用,从而发挥解毒的作用[20]。有研究[10]报道,FZJDQYF联合顺铂能够改善肺癌小鼠免疫功能,抑制肿瘤细胞免疫逃逸。研究[7-9]表明,扶正解毒祛瘀法联合西医治疗可以提高晚期NSCLC患者的临床疗效,有效控制疾病恶化进程,改善患者的生活质量和中医证候评分,改善机体免疫功能状态,并且有助于降低肿瘤标志物CEA、CYFRA21-1的水平,抑制肿瘤细胞活性,减少放化疗后所致血液毒性和胃肠道方面不良反应的发生,起到减毒增效的作用。
本研究结果显示,谷氨酰胺能够逆转顺铂诱导的A549细胞死亡,说明A549细胞可能更倾向于利用谷氨酰胺代谢来抑制顺铂诱导的细胞死亡。同时研究发现,A549/DDP细胞OCR、NADPH/NADP+明显高于A549细胞,而ROS低于A549细胞,说明A549/DDP细胞通过增加OCR、NADPH/NADP+以及降低ROS维持自身生长需求。已有研究[18]发现,谷氨酰胺通过促进NADPH的生成和抑制ROS的产生抑制肺癌细胞顺铂耐药。本研究发现,FZJDQYF通过抑制A549/DDP细胞对谷氨酰胺的摄取,降低OCR、NADPH/NADP+以及升高ROS水平,抑制A549/DDP细胞顺铂耐药。此外,谷氨酰胺代谢相关蛋白检测结果显示,FZJDQYF显著降低了顺铂诱导的A549/DDP细胞SLC1A5、GLS的表达,这进一步说明了FZJDQYF能够抑制A549/DDP细胞顺铂耐药,可能是抑制谷氨酰胺的摄取和分解代谢,从而使耐药细胞无法满足自身生长的能量需求,进而抑制了耐药性。A549/DDP细胞的耐药相关蛋白MRP2、MDR1、Pgp和LRP的检测结果显示,FZJDQYF能够明显抑制A549/DDP细胞耐药相关蛋白MRP2、MDR1、Pgp和LRP的表达。
综上所述,FZJDQYF能够抑制NSCLC细胞对谷氨酸的摄取,改变谷氨酸代谢,从而抑制NSCLC细胞顺铂耐药。本研究为FZJDQYF增敏顺铂治疗NSCLC提供了更充分的理论依据。然而本研究结果是基于体外研究获得的,有待于开展体内研究进一步论证。
| [1] |
THAI AA, SOLOMON BJ, SEQUIST LV, et al. Lung cancer[J]. Lancet, 2021, 398(10299): 535-554. DOI:10.1016/s0140-6736(21)00312-3 |
| [2] |
彭标, 杨相辉, 蒋莎莉, 等. SMARCA4缺陷型非小细胞肺癌的临床特征, 治疗和预后分析[J]. 中国医科大学学报, 2023, 52(7): 662-666. DOI:10.12007/j.issn.0258-4646.2023.07.018 |
| [3] |
WANG CQ, ZHENG XT, CHEN XF, et al. The optimal adjuvant strategy of aidi injection with gemcitabine and cisplatin in advanced non-small cell lung cancer: a meta-analysis of 70 randomized controlled trials[J]. Front Pharmacol, 2021, 12: 582447. DOI:10.3389/fphar.2021.582447 |
| [4] |
HAN XL, WANG DY, YANG L, et al. Activation of polyamine catabolism promotes glutamine metabolism and creates a targetable vulnerability in lung cancer[J]. Proc Natl Acad Sci USA, 2024, 121(13): e2319429121. DOI:10.1073/pnas.2319429121 |
| [5] |
WU YY, LAW YY, HUANG YW, et al. Glutamine metabolism controls amphiregulin-facilitated chemoresistance to cisplatin in human chondrosarcoma[J]. Int J Biol Sci, 2023, 19(16): 5174-5186. DOI:10.7150/ijbs.86116 |
| [6] |
胡金焕, 刘经选, 王兰, 等. 基于PGE2/COX-2信号通路探究扶正祛瘀解毒方对结肠癌细胞增殖, 凋亡, 迁移和侵袭的影响[J]. 中国老年学杂志, 2024, 44(2): 392-396. DOI:10.3969/j.issn.1005-9202.2024.02.039 |
| [7] |
杨佩颖, 李小江, 张瑶, 等. 扶正解毒祛瘀法方药择时给药防治非小细胞肺癌化疗所致骨髓抑制的临床研究[J]. 天津中医药, 2016, 33(5): 265-269. DOI:10.11656/j.issn.1672-1519.2016.05.03 |
| [8] |
王元, 王晓蓓, 任爽. 地西他滨+DAG方案联合扶正解毒祛瘀法治疗老年急性髓系白血病患者的临床疗效[J]. 中国医科大学学报, 2020, 49(5): 414-418. DOI:10.12007/j.issn.0258-4646.2020.05.007 |
| [9] |
朱津丽, 李小江, 贾英杰. 贾英杰教授运用"扶正解毒祛瘀法"在非小细胞肺癌维持期的治疗经验[J]. 天津中医药, 2019, 36(8): 739-742. DOI:10.11656/j.issn.1672-1519.2019.08.04 |
| [10] |
罗洋, 王芳, 赵辰辰. 扶正解毒祛瘀方联合顺铂对Lewis肺癌小鼠Th1/Th2免疫平衡的影响[J]. 现代中西医结合杂志, 2025, 34(7): 884-888. DOI:10.3969/j.issn.1008-8849.2025.07.002 |
| [11] |
张珂珂, 白豪, 吕金宇, 等. 基于血清药理学的肝龙胶囊含药血清制备方法的初步探究[J]. 中国病理生理杂志, 2024, 40(5): 956-960. DOI:10.3969/j.issn.1000-4718.2024.05.023 |
| [12] |
KRYCZKA J, KRYCZKA J, CZARNECKA-CHREBELSKA KH, et al. Molecular mechanisms of chemoresistance induced by cisplatin in NSCLC cancer therapy[J]. Int J Mol Sci, 2021, 22(16): 8885. DOI:10.3390/ijms22168885 |
| [13] |
HOSSIAN AKMN, ZAHRA FT, POUDEL S, et al. Advanced bioinformatic analysis and pathway prediction of NSCLC cells upon cisplatin resistance[J]. Sci Rep, 2021, 11: 6520. DOI:10.1038/s41598-021-85930-y |
| [14] |
QIN L, CHENG XY, WANG SJ, et al. Discovery of novel aminobutanoic acid-based ASCT2 inhibitors for the treatment of non-small-cell lung cancer[J]. J Med Chem, 2024, 67(2): 988-1007. DOI:10.1021/acs.jmedchem.3c01093 |
| [15] |
LI LP, LU MH, WANG H, et al. A novel MMP-9 inhibitor exhibits selective inhibition in non-small-cell lung cancer harboring EGFR T790M mutation by blocking EGFR/STAT3 signaling pathway[J]. Bioorg Chem, 2025, 159: 108393. DOI:10.1016/j.bioorg.2025.108393 |
| [16] |
LUO H, PENG JM, YUAN YX. CircRNA OXCT1 promotes the malignant progression and glutamine metabolism of non-small cell lung cancer by absorbing miR-516b-5p and upregulating SLC1A5[J]. Cell Cycle, 2023, 22(10): 1182-1195. DOI:10.1080/15384101.2022.2071565 |
| [17] |
CAI Y, DONG ZY, WANG JY. Circ_0000808 promotes the development of non-small cell lung cancer by regulating glutamine metabolism via the miR-1827/SLC1A5 axis[J]. World J Surg Oncol, 2022, 20(1): 329. DOI:10.1186/s12957-022-02777-x |
| [18] |
刘文俊. 基于谷氨酰胺代谢重编程探讨四君子汤抑制p62/Keap1/Nrf2通路诱导铁死亡改善NSCLC顺铂耐药[D]. 沈阳: 辽宁中医药大学, 2023.
|
| [19] |
李依霖, 叶军, 何连栋, 等. lncRNA ATP6V1B1-AS1对非小细胞肺癌增殖与侵袭的作用及其机制[J]. 中国医科大学学报, 2023, 52(1): 38-45. DOI:10.12007/j.issn.0258-4646.2023.01.008 |
| [20] |
彭蓓, 李仁廷, 严强东, 等. 白花蛇舌草治疗非小细胞肺癌的药理机制及研究进展[J]. 辽宁中医药大学学报, 2024, 26(10): 174-179. DOI:10.13194/j.issn.1673-842x.2024.10.035 |
 2026, Vol. 55
2026, Vol. 55




